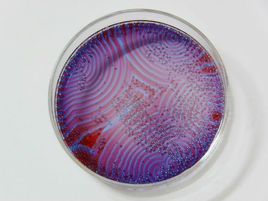
振盪反應

概述
振盪反應
振盪反應化學振盪反應是具有非線性動力學微分速率方程,是在開放體系中進行的遠離平衡的一類反應。體系與外界環境交換物質和能量的同時,通過採用適當的有序結構狀態耗散環境傳來的物質和能量。這類反應與通常的化學反應不同,它並非總是趨向於平衡態。
歷史
德國科學家李普曼Gabriel Lippmann於1876年實驗室配製溶液時碰巧發現一顆汞珠在溶液中自發地不斷收縮、擴張,如心臟的跳動一般。
1921年,伯克利加州大學的布雷(Bray,William)在用碘作催化劑使過氧化氫分解為水和氧氣時,第一次發現了振盪式的化學反應。但依據經典熱力學第二定律,認為任何化學反應只能走向退化的平衡態,因而當時的化學家否定了這個發現。
1952年,英國數學家圖靈通過數學計算的方法,在理論上預見了化學振盪這類現象的可能性。
1958年,俄國化學家別洛索夫(Belousov) 和扎鮑廷斯基(Zhabotinskii)首次報導了以金屬鈰作催化劑,檸檬酸在酸性條件下被溴酸鉀氧化時可呈現化學振盪現象:溶液在無色和淡黃色兩種狀態間進行著規則的周期振盪。該反應即被稱為Belousov- Zhabotinskii反應,簡稱B-Z反應。
1959年,B.P.Belousov首先觀察到並隨後為A.M.Zhabotinsky深入研究,丙二酸在溶液有硫酸鈰的酸性溶液中被溴酸鉀氧化的反應,隨後人么發現了一大批可呈現化學振盪反應現象的含溴酸鹽的反應系統。人們稱之為B-Z反應。
1969年,現代動力學奠基人普里戈金提出耗散結構理論,人們才清楚的認識到振盪反應產生的原因:當體系遠離平衡態時,即在非平衡非線性區,無序的均勻態並不總是穩定的。在特定的動力學條件下,無序的均勻定態可以失去穩定性,產生時空有序的狀態,這種狀態稱之為耗散結構。例如濃度隨時間有序的變化(化學振盪),濃度隨時間和空間有序的變化(化學波)等。耗散結構理論的建立為振盪反應提供了理論基礎,從此,振盪反應贏得了重視,它的研究得到了迅速發展。
化學振盪是一類機理非常複雜的化學過程,Field、Koros、Noyes三位科學家經過四年的努力,於1972年提出俄勒岡(FKN)模型,用來解釋並描述B-Z振盪反應的很多性質。該模型包括20個基元反應步驟,其中三個有關的變數通過三個非線性微分方程組成的方程組聯繫起來,該模型如此複雜以至20世紀的數學尚不能一般地解出這類問題,只能引入各種近似方法。
原因與條件
1977年諾貝爾獎獲得者比利時化學家Prigogine的工作最為重要。1945年提出了最小熵產生原理, 從熱力學上證明了在近離平衡時不可能發生振盪反應。這樣就促使人們去研究一些遠離平衡態的系統。1969年他領導下的布魯塞爾學派又提出了著名的耗散結構dissipative structures理論。從熱力學上證明了化學振盪反應的發生是可能的。生物體就是這樣一種體系。
所謂振盪反應(也稱搖擺反應),是指一些自催化反應有可能使反應體系中某些物質的濃度隨時間或空間發生周期性的變化,即發生化學振盪。若維持化學振盪的進行,必須不斷補充反應物,否則的話,反應的振盪即將停止。振盪現象的發生必須滿足以下條件:
(a)反應必須是敞開體系且遠離平衡態;
(b)反應歷程中應包含自催化的步驟;
(c)體系必須能有兩個穩態存在,即具有雙穩定性。在生物化學中也存在振盪現象,如動物心臟的有節律的跳動,在新陳代謝過程中占重要地位的糖酵解反應中,許多中間化合物和酶的濃度也是隨時間而周期性的變化。所謂生物鐘也是一種振盪現象,實際上生態平衡離不開振盪現象。
實例
先配製[I]、[II]、[III]三種溶液:
[I]——400mL 30%H2O2溶液加水稀釋至1L;
[II]——(42.8gKIO3 + 40mL 2mol·L-1H2SO4)加水稀釋至1L;
[III]——(15.6g丙二酸 + 3.38gMnSO4·H2O + 0.3g澱粉)加水稀釋至1L。
把[I]、[II]、[III]溶液在攪拌下等體積混合,溶液顏色呈現“無色→藍黑色→無色→藍黑色→……”的周期性變化,亦即反應體系在兩種情況之間震盪。如果能不斷加入反應物和不斷排出產物(即保持體系遠離平衡態),其震盪將持續下去,反之震盪周期將逐漸變長,直至溶液維持藍黑色。此化學震盪的主要反應為:
5H2O2 + 2HIO3 I2 + 5O2↑+ 6H2O
I2的形成積集到一定濃度會使澱粉變藍,而過量的H2O2又會氧化I2:
5H2O2 + I2 —→ 2HIO3 + 4H2O
使澱粉溶液褪色。HIO3的形成積集到一定濃度又引發與H2O2新一輪反應的發生。所以淨反應為:
2H2O2 —→ O2↑+ 2H2O
其間丙二酸的作用是可與I2反應產生少量I—:
I2 + CH2(COOH)2 —→ ICH(COOH)2 + H+ + I-
I2 + ICH(COOH)2 —→ I2C(COOH)2 + H+ + I-
I—對H2O2與HIO3的反應有阻化作用,過量的I—則被IO3—氧化:
5I- + IO3- + 6H+ —→ 3I2 + 3H2O
另外,一些振盪反應還在反應容器中不同部位出現溶液濃度不均勻的空間有序結構,展現出同心圓形或鏇轉螺鏇狀的捲曲花紋波。無序怎么會自發走向有序?1969年比利時化學家Prigogine經過近20年的研究,提出了耗散結構理論,全面、深入地揭示了化學震盪現象的本質。
操作注意事項:
搖擺反應中使用量筒移取三個溶液時,儘量使體積相同,並同時加入,否則將導致部分現象不明顯或變化太快。
意義套用前景
反應振盪器的設計和機理研究:尋找靈敏度高、選擇性好的反應體系. 研究這些振盪反應機理可為非線性科學的建立、發展起推動作用。
振盪反應的耦合: 振盪反應的耦合對人們揭示生物體系的複雜性具有重大的意義。如從單酶體系向多酶體系發展,因為生物體內的振盪反應都是屬於多酶體系的。
藥物對振盪反應體系的影響研究:通過研究藥物對化學振盪反應產生的干擾、對生命系統的周期性現象更深刻的認識,可為醫學的發展提供重要信息。
測定、研究BZ化學振盪反應可採用離子選擇性電極法、分光光度法和電化學等方法。

